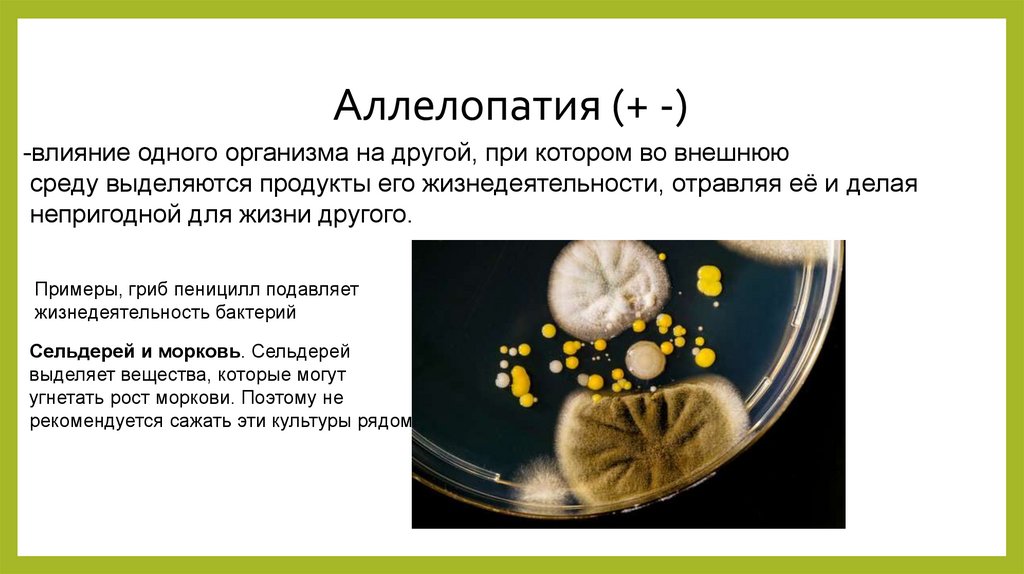

Similar presentations:
Антибиоз. Конкуренция
1.
АНТИБИОЗ.КОНКУРЕНЦИЯ
2.
Антибиозом называют такую форму взаимоотношений, при которойлибо обе взаимодействующие популяции ограничивают возможности
развития друг друга, либо одна из них угнетает развитие другой.
Неблагоприятное влияние одних популяций на другие может
проявляться в разных формах.
3.
Аменсализм (+ -)-взаимоотношения, при которых один организм воздействует на другой и
подавляет его жизнедеятельность, а сам не испытывает никаких отрицательных
влияний со стороны подавляемого.
Типичным примером аменсализма можно
считать ситуацию, при которой высокие
кроны
деревьев угнетают рост низкорослых
растений и мхов за счёт частичного
перекрывания доступа
солнечного света
4.
Аллелопатия (+ -)-влияние одного организма на другой, при котором во внешнюю
среду выделяются продукты его жизнедеятельности, отравляя её и делая
непригодной для жизни другого.
Примеры, гриб пеницилл подавляет
жизнедеятельность бактерий
Сельдерей и морковь. Сельдерей
выделяет вещества, которые могут
угнетать рост моркови. Поэтому не
рекомендуется сажать эти культуры рядом
5.
КонкуренцияАллелопатия может проявлятся не только при аменсалистических взаимодействиях, но
и во время конкуренции организмов за различные ресурсы.
Конкуренция
подразумевает под собой любые антагонистические (взаимно угнетающие) отношения,
связанные с борьбой за существование, за доминирование, за пищу, пространство и другие
ресурсы между организмами или популяциями, нуждающимися в одних и тех же ресурсах.
6.
Внутривидовая конкуренция-Это борьба за одни и те же ресурсы происходящие между особями
одного и того же вида. Она является весьма важным фактором
саморегулирования популяций.(- -)
Пример, борьба двух белых медведей за самку, борьба
двух растений одного вида за солнечный свет,
борьба амурских тигров за пищу
У некоторых организмов внутривидовой
конкуренции за пространство
сформировался интересный тип поведения
его называют территориальность.
7.
Территориальность-это наличие участка, охраняемого данным животным или группой животных.
Территориальность свойственно многим видам птиц некоторым рыбам и другим животным.
Например, у птиц территориальный тип поведения
проявляется следующим образом: в начале сезона
размножения самец выбирает участок обитания и
защищает его от вторжения самцов того же вида.
Заметим, что громкие голоса самцов, которые мы
слышим весной, сигнализируют лишь о праве
собственности на приглянувшийся участок, а вовсе не
помогает певцу ,вопреки распространённому
заблуждению привлечь самку. Таким образом,
территориальное поведение можно считать
экологическим регулятором, поскольку он
одинаково позволяет избегать как перенаселение, так и
недостаточной населённости.
8.
Межвидовая конкуренция-взаимно отрицательные отношения совместно проживающих
близкородственных или сходных видов.(- -)
Формы проявления межвидовой конкуренции могут быть весьма различными
от жестокой борьбы до почти мирного сосуществования. Но если два вида с одинаковыми
потребностями оказываются в одном сообществе, рано или поздно один конкурент вытеснит другого.
Конкуренция между медведями и волками за
доступ к общей добыче. В лесных экосистемах
эти виды охотятся на оленей и других диких крупных
животных и, следовательно, конкурируют за доступ к
пище.
9.
Пример,, два вида клевера обитают в одной среде с одинаковыми температурой, освещением,почвенными условиями. Один вид (Triboliumrepens) быстрее проходит стадии развития и скорее
формирует листву. Другой же вид (Т. fragiferum), обладая более длинными черешками и выше
посаженными листьями, переходит в верхний ярус и тем самым избегает затенения со стороны
своего соседа.

biology
biology








